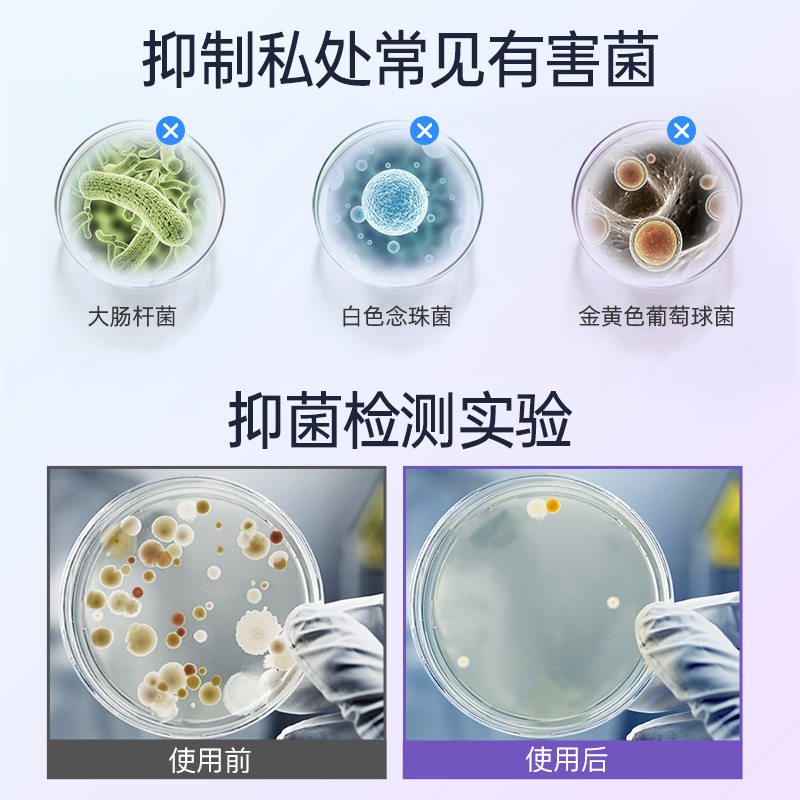

【妇炎洁】亲爱的闺蜜本草精华抑菌洗液200ml
洗洗更健康,妇炎洁洗护液!弱碱性配方,温和不刺激,洁阴、养阴、护阴三效合一,有效缓解异味,避免交叉感染!妇炎洁女性私处清洗液植物本草洗护液护理男女士专用舰店官网正品洗护清洁剂_卫生巾_纸_香薰

妇炎洁女性私处清洗液植物本草洗护液护理男女士专用舰店官网正品
PS:本站资源来源于网络,不保证外部链接的准确性和完整性,同时,对于该外部链接的指向,不由本站实际控制,收录时,该网页上的内容,都属于合规合法,后期网页的内容如出现违规,可以直接联系网站管理员进行删除,本站不承担任何责任。
相关标签:
# 妇炎洁恒方专卖店
# 私处洗液
# 洗护清洁剂
# 卫生巾
# 纸
# 香薰